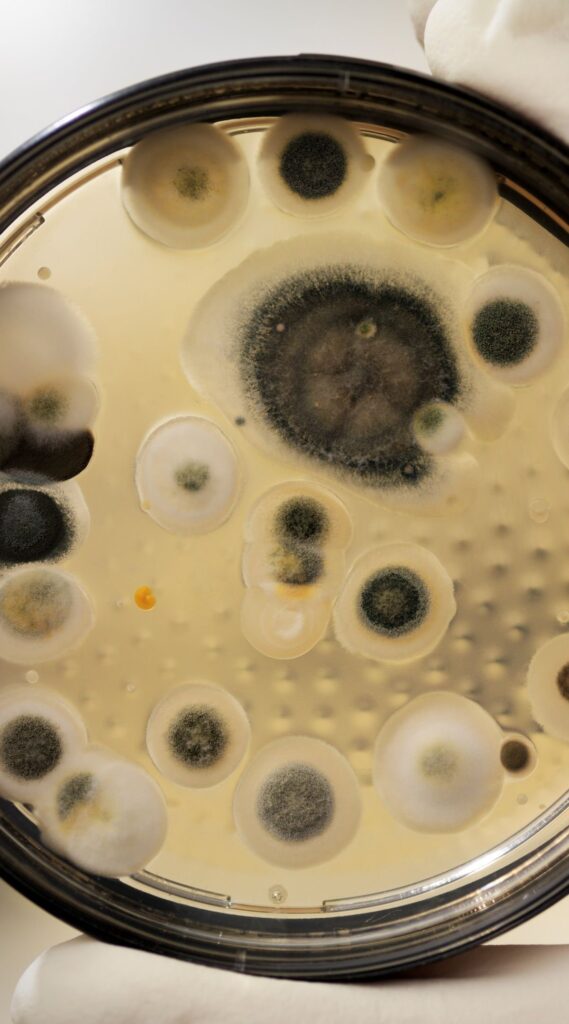

O mofo é uma formação de vários tipos de fungos filamentosos comuns na natureza ou em casa. Por trás de sua aparência inofensiva — e estranha — esses microrganismos podem ser uma dor de cabeça. Embora boa parte deles não seja letal aos humanos, podem desencadear problemas de saúde que demandam uma ida ao médico.
Em geral, cada cor do mofo tem associação com uma espécie específica desse conjunto de fungos. Por mais que haja a ideia de que a cor do mofo determina o quão perigoso ele é, as coisas não são bem assim.
O mofo verde dos pães
Na hora de comer aquele pãozinho durante a tarde você já deve ter reparado em um mofo azul que toma conta de bolos e outros alimentos. Normalmente esse mofo verde é do tipo Aspergillus, Penicillium e Cladosporium, que formam a tríade dos mofos mais comuns de se encontrar em casa.
O Aspergillus é uma das espécies mais associadas a doenças em humanos, representando reações alérgicas e certas infecções locais. Contudo, o fungo pode liberar esporos que quando entram nos vasos sanguíneos podem causar doenças invasivas, como necrose e infarto.

Já o Cladosporium faz sua colônia em móveis, estofados, madeiras e torneiras. Esse tipo de mofo pode causar coriza, congestão nasal, tosse, irritação nos olhos, etc.
Mofo azul da laranja
Aquele mofo esverdeado encontrado na casca da laranja é causado pelo Penicillium, e também podem ser encontrados em tecidos, couro e outros tipos de alimentos. O mofo tem relação com um certo antibiótico chamado Penicilina, descoberto por Alexander Fleming em 1928 ao entender que o fungo combate infecções bacterianas.
O Penicillium se espalha pelo ar, portanto evite movimentar objetos ou alimentos contaminados com o fungo rapidamente, já que ele solta uma poeirinha usada para sua dispersão. Quando em contato com humanos, pode causar irritação na pele, crises de asma e reações alérgicas.

Esse fungo também é usado biologicamente em determinados alimentos, como em culturas para a confecção de queijos como gorgonzola.
Mofo preto
Um dos mais temidos, o mofo preto se torna um grande problema em casas com muita umidade. Geralmente é associado ao fungo Stachybotrys chartarum em paredes, placas de madeira ou gesso. Há também o Aureobasidium, que costuma aparecer nos banheiros, próximo ao chuveiro.
Esses mofos pretos podem intensificar casos de asma, quadros de alergia e asma. Nesses casos é importante aplicar materiais específicos contra esse tipo de fungo ou procurar auxílio de um profissional para a remoção.

Mofo em casa não é legal
Por mais que seja inevitável, ter mofo em casa não é uma boa notícia. É preciso conservar melhor os alimentos e se atentar para o nível de umidade da casa. Caso tenha dúvidas sobre o tipo de mofo que está dando problemas, é imprescindível procurar um especialista e evitar mexer nesses microrganismos se você já tem problemas de saúde.
Fonte.: TecMundo